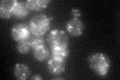
YPL195W
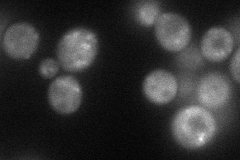
YPL195W
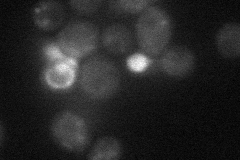
YPL195W
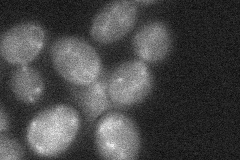
YPL195W
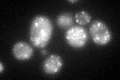
YPL195W
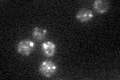
YPL195W

View description
Delta adaptin-like subunit of the clathrin associated protein complex (AP-3); functions in transport of alkaline phosphatase to the vacuole via the alternate pathway, suppressor of loss of casein kinase 1 function
Localization:
Intensity:
Fold change:
Significance:
-
C’ GFP library in SD
punctate40.03 -
N' NOP1pr-GFP in SD
punctate66.5897 -
N' TEF2pr-mCherry in SD
punctate16.1094 -
N' NATIVEpr-GFP in SD

punctate26.7272 -
N' TEF2pr-VC and Cyto-VN in SD
below threshold27.98 -
C’ GFP library in SD+DTT
punctate41.861.04No -
C’ GFP library in SD+H2O2

punctate35.170.87No -
C’ GFP library in Starvation Media
punctate38.010.94No -
C’ GFP library on the background of Pup2-DaMP

punctate -
C’ GFP library on the background of CCT mutant

punctate44.87861.12096No
